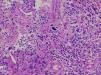

Glioblastoma multiforme (GBM) is the most common primary brain tumor, but pure intraventricular location is extremely rare for GBM in neurosurgical practice. To our knowledge, there are only 19 reported cases to date. We present an additional case of intraventricular GBM with detailed clinical course, radiological and pathological findings.
El glioblastoma multiforme (GBM) es el tumor cerebral primario más común que existe, pero una localización netamente intraventricular es muy rara en la práctica neuroquirúrgica. Según nuestro conocimiento, hasta la fecha solo se han publicado 19 casos intraventriculares. Presentamos un nuevo caso de GBM intraventricular con una descripción detallada de la evolución clínica y los hallazgos patológicos y radiológicos.
Artículo

Si es la primera vez que accede a la web puede obtener sus claves de acceso poniéndose en contacto con Elsevier España en suscripciones@elsevier.com o a través de su teléfono de Atención al Cliente 902 88 87 40 si llama desde territorio español o del +34 932 418 800 (de 9 a 18h., GMT + 1) si lo hace desde el extranjero.
Si ya tiene sus datos de acceso, clique aquí.
Si olvidó su clave de acceso puede recuperarla clicando aquí y seleccionando la opción "He olvidado mi contraseña".